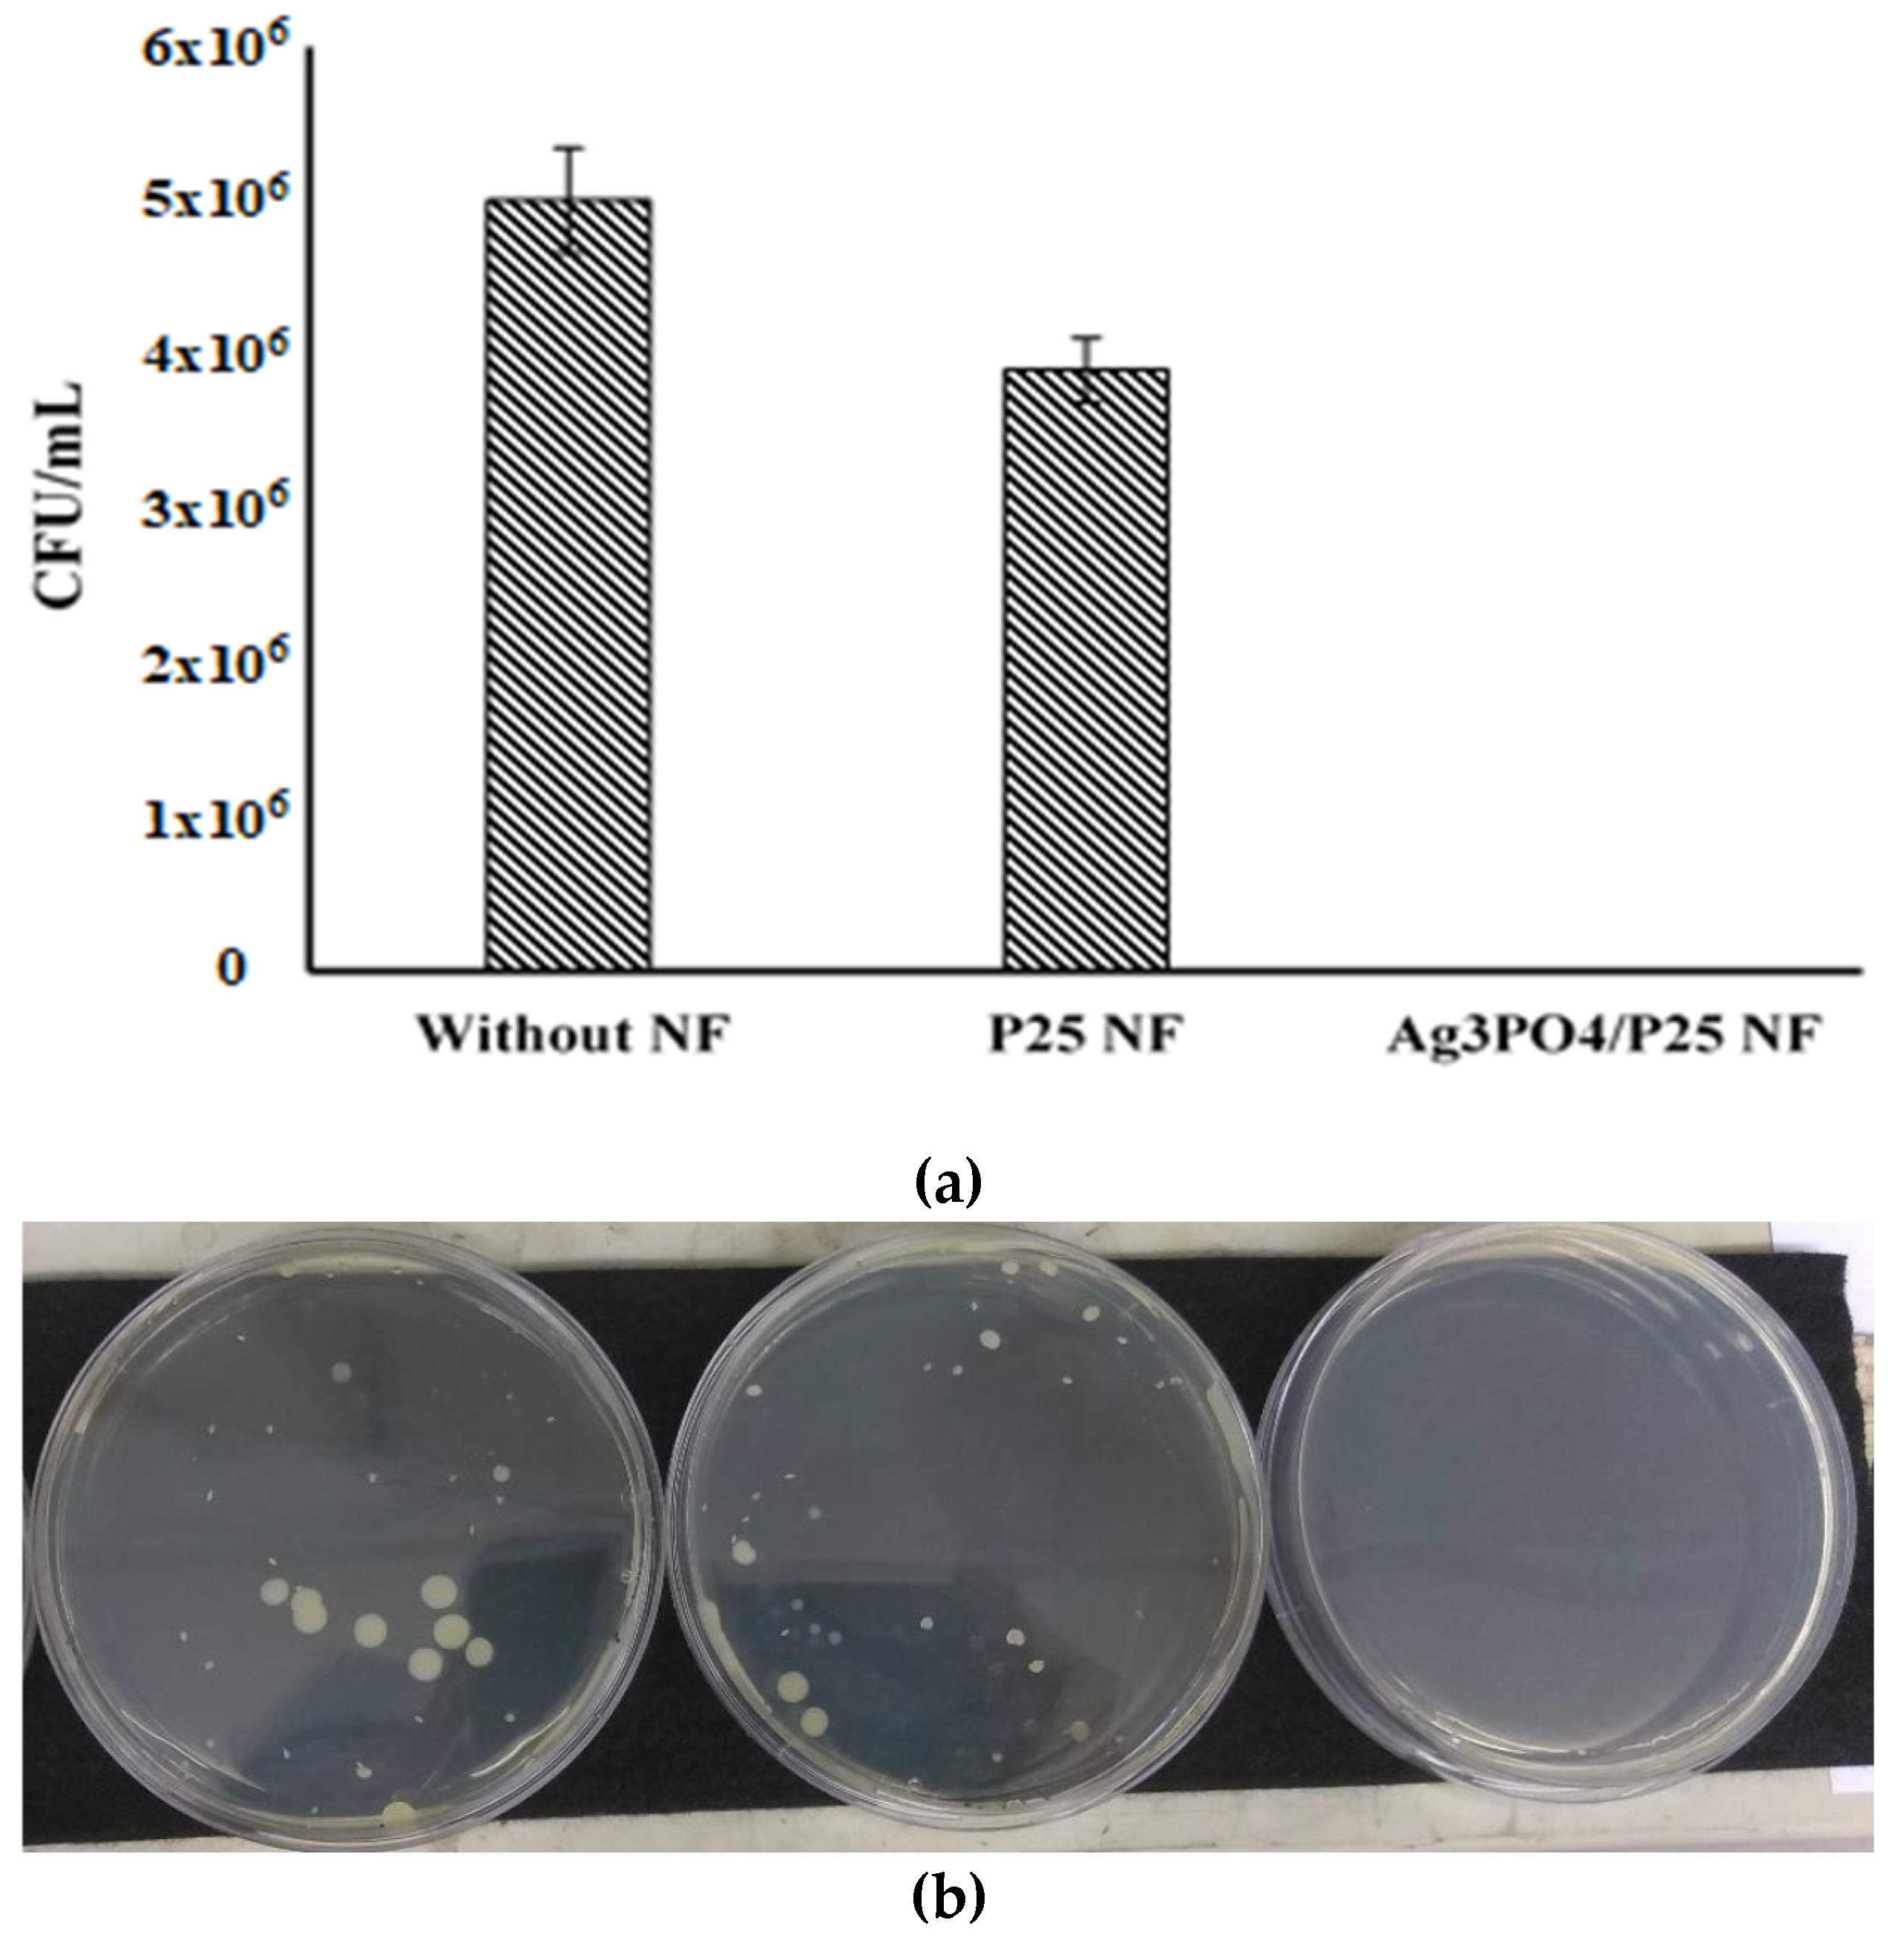
Catalysts 10 00784 g008

Bi-Polymer Electrospun Nanofibers Embedding Ag3PO4/P25 Composite for Efficient Photocatalytic Degradation and Anti-Microbial Activity
Abstract
1. Introduction
2. Results and Discussion
2.1. Characterization of Synthesized Nanofibers
2.2. Band Gap Analysis
2.3. Photocatalytic Degradation of Methyl Orange by Ag3PO4/P25 Nanofibers
2.4. Stability of Ag3PO4/P25 Nanofibers
2.5. Antibacterial Efficiency of Ag3PO4/P25 Composite Nanofibers
2.6. Tertiary Treatment of Synthetic Textile Secondary Effluent Using Plug Flow Reactor (PFR)
- (1)
- Attenuating the light penetration due to deeper solution induced by inorganic salts and dyes mixture, taking part as an inner filter [40].
- (2)
- Scavenging the OH° radicals as well as other oxidizing species.
- (3)
- Competition among inorganic salts and dye molecules for adsorption on active sites of the photocatalyst [41].
3. Materials and Methods
3.1. Reagents
3.2. Preparation of Ag3PO4/P25 Composite
3.3. Preparation of Ag3PO4/P25 Nanofibers
3.4. Material Characterization
3.5. Photocatalytic Degradation Study
3.6. Evaluation of Antibacterial Activity
3.7. Plug Flow Reactor (PFR) Design and Operational Conditions
4. Conclusions
Author Contributions
Funding
Acknowledgments
Conflicts of Interest
References
- Zhang, Z.-G.; Liu, H.; Wang, X.-X.; Zhang, J.; Yu, M.; Ramakrishna, S.; Long, Y.-Z.; Zhang, Z.-G.; Liu, H.; Wang, X.-X.; et al. One-Step Low Temperature Hydrothermal Synthesis of Flexible TiO2/PVDF@MoS2 Core-Shell Heterostructured Fibers for Visible-Light-Driven Photocatalysis and Self-Cleaning. Nanomaterials 2019, 9, 431. [Google Scholar] [CrossRef] [PubMed]
- Ali, I.; Kim, J.-O. Continuous-Flow Photocatalytic Degradation of Organics Using Modified TiO2 Nanocomposites. Catalysts 2018, 8, 43. [Google Scholar] [CrossRef]
- Katal, R.; Kholghi Eshkalak, S.; Masudy-panah, S.; Kosari, M.; Saeedikhani, M.; Zarinejad, M.; Ramakrishna, S. Evaluation of Solar-Driven Photocatalytic Activity of Thermal Treated TiO2 under Various Atmospheres. Nanomaterials 2019, 9, 163. [Google Scholar] [CrossRef] [PubMed]
- Giovannetti, R.; Rommozzi, E.; Zannotti, M.; D’Amato, C.A. Recent advances in graphene based TiO2 nanocomposites (GTiO2Ns) for photocatalytic degradation of synthetic dyes. Catalysts 2017, 7, 305. [Google Scholar] [CrossRef]
- Taheri, M.E.; Petala, A.; Frontistis, Z.; Mantzavinos, D.; Kondarides, D.I. Fast photocatalytic degradation of bisphenol A by Ag3PO4/TiO2composites under solar radiation. Catal. Today 2017, 280, 99–107. [Google Scholar] [CrossRef]
- Yi, Z.; Ye, J.; Kikugawa, N.; Kako, T.; Ouyang, S.; Stuart-williams, H.; Yang, H.; Cao, J.; Luo, W.; Li, Z.; et al. An orthophosphate semiconductor with photooxidation properties under visible-light irradiation. Nat. Mater. 2010, 9, 559–564. [Google Scholar] [CrossRef] [PubMed]
- Rosman, N.; Wan Salleh, W.N.; Aziz, F.; Ismail, A.F.; Harun, Z.; Bahri, S.S.; Nagai, K. Electrospun Nanofibers Embedding ZnO/Ag2CO3/Ag2O Heterojunction Photocatalyst with Enhanced Photocatalytic Activity. Catalysts 2019, 9, 565. [Google Scholar] [CrossRef]
- Lee, C.G.; Javed, H.; Zhang, D.; Kim, J.H.; Westerhoff, P.; Li, Q.; Alvarez, P.J.J. Porous Electrospun Fibers Embedding TiO2 for Adsorption and Photocatalytic Degradation of Water Pollutants. Environ. Sci. Technol. 2018, 52, 4285–4293. [Google Scholar] [CrossRef] [PubMed]
- Wang, C.; Yin, J.; Han, S.; Jiao, T.; Bai, Z.; Zhou, J.; Zhang, L.; Peng, Q. Preparation of Palladium Nanoparticles Decorated Polyethyleneimine/Polycaprolactone Composite Fibers Constructed by Electrospinning with Highly Efficient and Recyclable Catalytic Performances. Catalysts 2019, 9, 559. [Google Scholar] [CrossRef]
- Kalantari, M.; Du, R.; Ayranci, C.; Boluk, Y. Effects of interfacial interactions and interpenetrating brushes on the electrospinning of cellulose nanocrystals-polystyrene fibers. J. Colloid Interface Sci. 2018, 528, 419–430. [Google Scholar] [CrossRef] [PubMed]
- Doh, S.J.; Kim, C.; Lee, S.G.; Lee, S.J.; Kim, H. Development of photocatalytic TiO2 nanofibers by electrospinning and its application to degradation of dye pollutants. J. Hazard. Mater. 2008, 154, 118–127. [Google Scholar] [CrossRef] [PubMed]
- Cantarella, M.; Sanz, R.; Buccheri, M.A.; Ruffino, F.; Rappazzo, G.; Scalese, S.; Impellizzeri, G.; Romano, L.; Privitera, V. Immobilization of nanomaterials in PMMA composites for photocatalytic removal of dyes, phenols and bacteria from water. J. Photochem. Photobiol. A Chem. 2016, 321, 1–11. [Google Scholar] [CrossRef]
- Haider, A.; Khan, S.J.; Saqib Nawaz, M.; Saleem, M.U. Effect of intermittent operation of lab-scale upflow anaerobic sludge blanket (UASB) reactor on textile wastewater treatment. Desalin. Water Treat. 2018, 136, 120–130. [Google Scholar]
- Bairamis, F.; Konstantinou, I.; Petrakis, D.; Vaimakis, T. Enhanced Performance of Electrospun Nanofibrous TiO2/g-C3N4 Photocatalyst in Photocatalytic Degradation of Methylene Blue. Catalysts 2019, 9, 880. [Google Scholar] [CrossRef]
- Hu, D.; Xiao, Y.; Liu, H.; Wang, H.; Li, J.; Zhou, B. Loading of Au/Ag bimetallic nanoparticles within electrospun PVA/PEI nano fi bers for catalytic applications. Colloids Surf. A 2018, 552, 9–15. [Google Scholar] [CrossRef]
- Khan, M.Q.; Id, D.K.; Ullah, S.; Waqas, M.; Malik, A.; Abbasi, R.; Saito, Y.; Id, C.Z.; Kim, I.S. Self-Cleaning Properties of Electrospun PVA/TiO2 and PVA/ZnO Nanofibers Composites. Nanomaterials 2018, 8, 644. [Google Scholar] [CrossRef] [PubMed]
- Keskinates, M.; Yilmaz, B.; Ulusu, Y.; Bayrakci, M. Electrospinning of novel calixarene-functionalized PAN and PMMA nanofibers: Comparison of fluorescent protein adsorption performance. Mater. Chem. Phys. 2018, 205, 522–529. [Google Scholar] [CrossRef]
- Sundaran, S.P.; Reshmi, C.R.; Sujith, A. Tailored design of polyurethane based fouling-tolerant nanofibrous membrane for water treatment. New J. Chem. 2018, 42, 1958–1972. [Google Scholar] [CrossRef]
- Chaudhuri, B.; Mondal, B.; Ray, S.K.; Sarkar, S.C. A novel biocompatible conducting polyvinyl alcohol (PVA)-polyvinylpyrrolidone (PVP)-hydroxyapatite (HAP) composite scaffolds for probable biological application. Colloids Surf. B Biointerfaces 2016, 143, 71–80. [Google Scholar] [CrossRef] [PubMed]
- Panthi, G.; Park, S.J.; Chae, S.H.; Kim, T.W.; Chung, H.J.; Hong, S.T.; Park, M.; Kim, H.Y. Immobilization of Ag3PO4 nanoparticles on electrospun PAN nanofibers via surface oximation: Bifunctional composite membrane with enhanced photocatalytic and antimicrobial activities. J. Ind. Eng. Chem. 2017, 45, 277–286. [Google Scholar] [CrossRef]
- Saud, P.S.; Pant, B.; Twari, A.P.; Ghouri, Z.K.; Park, M.; Kim, H.Y. Effective photocatalytic efficacy of hydrothermally synthesized silver phosphate decorated titanium dioxide nanocomposite fibers. J. Colloid Interface Sci. 2016, 465, 225–232. [Google Scholar] [CrossRef] [PubMed]
- Pattnaik, S.P.; Behera, A.; Martha, S.; Acharya, R.; Parida, K. Synthesis, photoelectrochemical properties and solar light-induced photocatalytic activity of bismuth ferrite nanoparticles. J. Nanoparticle Res. 2018, 20, 10. [Google Scholar] [CrossRef]
- Liu, H.; Li, D.; Yang, X.; Li, H. Fabrication and characterization of Ag3PO4/TiO2 heterostructure with improved visible-light photocatalytic activity for the degradation of methyl orange and sterilization of E. coli. Mater. Technol. 2019, 34, 192–203. [Google Scholar] [CrossRef]
- Scarsella, M.; Bracciale, M.P.; de Caprariis, B.; de Filippis, P.; Petrullo, A.; Pronti, L.; Santarelli, M.L. Improved photocatalytic properties of doped titanium-based nanometric oxides. Chem. Eng. Trans. 2017, 60, 133–138. [Google Scholar]
- Li, Y.; Zhao, H.; Yang, M. TiO2 nanoparticles supported on PMMA nanofibers for photocatalytic degradation of methyl orange. J. Colloid Interface Sci. 2017, 508, 500–507. [Google Scholar] [CrossRef] [PubMed]
- Yao, W.; Zhang, B.; Huang, C.; Ma, C.; Song, X.; Xu, Q. Synthesis and characterization of high efficiency and stable Ag3PO4/TiO2 visible light photocatalyst for the degradation of methylene blue and rhodamine B. solutions. J. Mater. Chem. 2012, 22, 4050. [Google Scholar] [CrossRef]
- Zhao, F.M.; Pan, L.; Wang, S.; Deng, Q.; Zou, J.J.; Wang, L.; Zhang, X. Ag3PO4/TiO2 composite for efficient photodegradation of organic pollutants under visible light. Appl. Surf. Sci. 2014, 317, 833–838. [Google Scholar] [CrossRef]
- Yu, H.; Jiao, Z.; Hu, H.; Lu, G.; Ye, J.; Bi, Y. Fabrication of Ag3PO4-PAN composite nanofibers for photocatalytic applications 3. R. Soc. Chem. 2013, 15, 4802–4805. [Google Scholar] [CrossRef]
- Al-Ghafri, B.; Lau, W.-J.; Al-Abri, M.; Goh, P.-S.; Ismail, A.F. Titanium dioxide-modified polyetherimide nanofiber membrane for water treatment. J. Water Process. Eng. 2019, 32, 100970. [Google Scholar] [CrossRef]
- Piccirillo, C.; Pinto, R.A.; Tobaldi, D.M.; Pullar, R.C.; Labrincha, J.A.; Pintado, M.M.E.; Castro, P.M.L. Light induced antibacterial activity and photocatalytic properties of Ag/Ag3PO4-based material of marine origin. J. Photochem. Photobiol. A Chem. 2014, 296, 40–47. [Google Scholar] [CrossRef]
- Dong, C.; Wang, Z.; Wu, J.; Wang, Y.; Wang, J.; Wang, S. A green strategy to immobilize silver nanoparticles onto reverse osmosis membrane for enhanced anti-biofouling property. Desalination 2017, 401, 32–41. [Google Scholar] [CrossRef]
- Nimkar, U. Sustainable Chemistry: A Solution to the Textile Industry in a Developing World. Curr. Opin. Green Sustain. Chem. 2017, 9, 13–17. [Google Scholar] [CrossRef]
- Wiszniowski, J.; Robert, D.; Surmacz-Gorska, J.; Miksch, K.; Malato, S.; Weber, J.-V. Solar photocatalytic degradation of humic acids as a model of organic compounds of landfill leachate in pilot-plant experiments: Influence of inorganic salts. Appl. Catal. B Environ. 2004, 53, 127–137. [Google Scholar] [CrossRef]
- American Public Health Association. APHA Method 4500-F: Standart Methods for the Examination of Water and Wastewater; American Public Health Association: Washington, DC, USA, 2012. [Google Scholar]
- Wang, H.; Huang, X.; Li, W.; Gao, J.; Xue, H.; Li, R.K.Y. TiO2 nanoparticle decorated carbon nano fi bers for removal of organic dyes. Colloids Surf. A 2018, 549, 205–211. [Google Scholar] [CrossRef]
- Diantoro, M.; Kusumaatmaja, A.; Triyana, K. Study on Photocatalytic Properties of TiO2 Nanoparticle in various pH condition. J. Phys. Conf. Ser. 2018, 1011, 012069. [Google Scholar]
- Bouanimba, N.; Laid, N.; Zouaghi, R.; Sehili, T. Effect of pH and inorganic salts on the photocatalytic decolorization of methyl orange in the presence of TiO2 P25 and PC500. Desalin. Water Treat. 2013, 1–13. [Google Scholar] [CrossRef]
- Kiwi, J.; Lopez, A.; Nadtochenko, V. Mechanism and Kinetics of the OH-Radical Intervention during Fenton Oxidation in the Presence of a Significant Amount of Radical Scavenger (Cl-). Environ. Sci. Technol. 2000, 34, 2162–2168. [Google Scholar] [CrossRef]
- Zhu, X.; Nanny, M.A.; Butler, E.C. Effect of inorganic anions on the titanium dioxide-based photocatalytic oxidation of aqueous ammonia and nitrite. J. Photochem. Photobiol. A Chem. 2007, 185, 289–294. [Google Scholar] [CrossRef]
- Grace, A.S.; Michael, S. Phytoplankton productivity in newly dug fish ponds within Lake Victoria wetlands (Uganda). Afr. J. Environ. Sci. Technol. 2010, 4, 365–370. [Google Scholar] [CrossRef][Green Version]
- Guillard, C.; Puzenat, E.; Lachheb, H.; Houas, A.; Herrmann, J.-M. Why inorganic salts decrease the TiO2 photocatalytic efficiency. Int. J. Photoenergy 2005, 7, 1–9. [Google Scholar] [CrossRef]
- Tayel, A.; Ramadan, A.R.; El Seoud, O.A. Titanium dioxide/graphene and titanium dioxide/graphene oxide nanocomposites: Synthesis, characterization and photocatalytic applications for water decontamination. Catalysts 2018, 8, 491. [Google Scholar] [CrossRef]
- Aljeboree, A.M.; Alshirifi, A.N.; Alkaim, A.F. Kinetics and equilibrium study for the adsorption of textile dyes on coconut shell activated carbon. Arab. J. Chem. 2017, 10, S3381–S3393. [Google Scholar] [CrossRef]

| Flow Rate (mL/h) | Turbidity (NTU) | Color Removal (%) | TOC (%) |
|---|---|---|---|
| 5 | 4.80 | MO: 21.0 | 86.00 |
| MB: 66.0 | |||
| 7 | 5.18 | MO: 19.0 | 82.69 |
| MB: 53.9 | |||
| 9 | 6.17 | MO: 16.7 | 54.63 |
| MB: 53.4 |
| Chemicals | Formula | Concentration (mg/L) |
|---|---|---|
| Dextrose (glucose) | C6H12O6 | 150 |
| Ammonium chloride | NH4Cl | 380 |
| Potassium dihydrogen phosphate | KH2PO4 | 43 |
| Methyl orange (MO) | C14H14N3NaO3S | 10 |
| Methylene blue (MB) | C16H18ClN3S | 10 |
© 2020 by the authors. Licensee MDPI, Basel, Switzerland. This article is an open access article distributed under the terms and conditions of the Creative Commons Attribution (CC BY) license (http://creativecommons.org/licenses/by/4.0/).
Share and Cite
Habib, Z.; Lee, C.-G.; Li, Q.; Khan, S.J.; Ahmad, N.M.; Jamal, Y.; Huang, X.; Javed, H. Bi-Polymer Electrospun Nanofibers Embedding Ag3PO4/P25 Composite for Efficient Photocatalytic Degradation and Anti-Microbial Activity. Catalysts 2020, 10, 784. https://doi.org/10.3390/catal10070784
Habib Z, Lee C-G, Li Q, Khan SJ, Ahmad NM, Jamal Y, Huang X, Javed H. Bi-Polymer Electrospun Nanofibers Embedding Ag3PO4/P25 Composite for Efficient Photocatalytic Degradation and Anti-Microbial Activity. Catalysts. 2020; 10(7):784. https://doi.org/10.3390/catal10070784
Chicago/Turabian StyleHabib, Zunaira, Chang-Gu Lee, Qilin Li, Sher Jamal Khan, Nasir Mahmood Ahmad, Yousuf Jamal, Xiaochuan Huang, and Hassan Javed. 2020. "Bi-Polymer Electrospun Nanofibers Embedding Ag3PO4/P25 Composite for Efficient Photocatalytic Degradation and Anti-Microbial Activity" Catalysts 10, no. 7: 784. https://doi.org/10.3390/catal10070784
APA StyleHabib, Z., Lee, C.-G., Li, Q., Khan, S. J., Ahmad, N. M., Jamal, Y., Huang, X., & Javed, H. (2020). Bi-Polymer Electrospun Nanofibers Embedding Ag3PO4/P25 Composite for Efficient Photocatalytic Degradation and Anti-Microbial Activity. Catalysts, 10(7), 784. https://doi.org/10.3390/catal10070784








